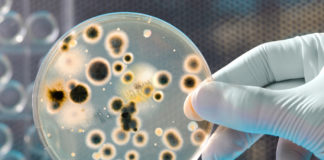
In crescita il mercato dei farmaci contro il Clostridium difficile

Tag: mercato
Indagine di mercato
Trend dell’industria farmaceutica italiana
Mercato, soprattutto estero, in espansione ma anche contrazione degli utili: una recente indagine dell’Area Studi Mediobanca fotografa la situazione dei nove maggiori gruppi farmaceutici italiani nel periodo 2009-2013
Italia: uno dei mercati europei più maturi
Nutraceutici in farmacia
In questo canale, la spesa ha raggiunto i 2,2 miliardi con un aumento del 7,3% nel 2014
Nei primi due mesi del 2015, il mercato commerciale è arrivato a coprire il 40% del fatturato delle farmacie con un aumento del 3,9%